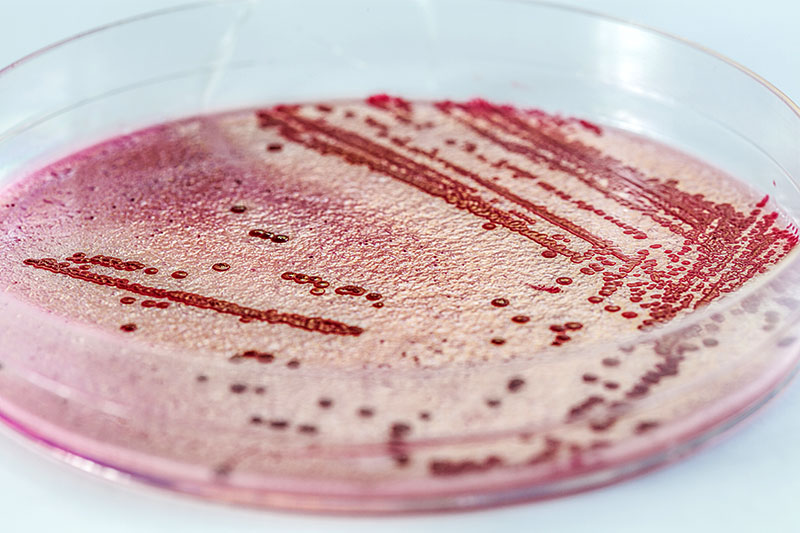

UV Tech Board is Under 3rd Party Antibacterial Test
2019/05/10 Celadon Tech -RDCeladon UV Tech Board (Mirror Anti-stretch Plastic Stone Board) develop a new formula that can physically destructed cell membrane and achieve antibacterial effect. Unlike chemical antibacterial method, physical method will have a longer warranty.
So far, the 3rd party is trying to cultivate 5 of the most comment bacteria on Celadon UV Tech Board. If no colonies are found, it will prove that this board will help us to beat the disease. We have passed the internal test before; thus, we believe that the result will must be great.
Press Release
New PPF DevelopingCutting Age PPF is Under Development, TPU PPF's performance with reasonable price.
Read More